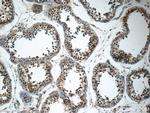
SPATA16 Antibody in Immunohistochemistry (Paraffin) (IHC (P))

Search
Proteintech
SPATA16 Polyclonal Antibody
{{$productOrderCtrl.translations['antibody.pdp.commerceCard.promotion.promotions']}}
{{$productOrderCtrl.translations['antibody.pdp.commerceCard.promotion.viewpromo']}}
{{$productOrderCtrl.translations['antibody.pdp.commerceCard.promotion.promocode']}}: {{promo.promoCode}} {{promo.promoTitle}} {{promo.promoDescription}}. {{$productOrderCtrl.translations['antibody.pdp.commerceCard.promotion.learnmore']}}
产品信息
17357-1-AP
种属反应
宿主/亚型
分类
类型
抗原
偶联物
形式
浓度
规格
纯化类型
保存液
内含物
保存条件
运输条件
产品详细信息
Immunogen sequence: EDIASVASF IETKLVTCYL RMRKPDLALN HAHRSIVLNP AYFRNHLRQA TVFRCLERYS EAARSAMIAD YMFWLGGGRE ESISKLIKLY WQAMIEEAIT RAESFSVMYT PFATKIRADK IEKVKDAFTK THPAYAEYMY TDLQALHMLP QTVDWSSFPP QQYLLTLGFK NKDDGKFLEK ISSRKLPIFT EHKTPFGLTR EDTVRQMETM GKRILPILDF IRSTQLNGSF PASSGVMEKL QYASLLSQLQ RVKEQSQVIN QAMAELATIP YLQDISQQEA ELLQSLMADA MDTLEGRRNN NERVWNMIQK VGQIEDFLYQ LEDSFLKTKK LRTARRQKTK MKRLQTVQQR (221-570 aa encoded by BC034496)
靶标信息
This gene encodes a testis-specific protein that belongs to the tetratricopeptide repeat-like superfamily. The encoded protein localizes to the Golgi apparatus and may play a role in spermatogenesis.
仅用于科研。不用于诊断过程。未经明确授权不得转售。
篇参考文献 (0)
生物信息学
蛋白别名: CDC68; FACT; FACTP140; FLJ10857; FLJ14010; spermatogenesis associated 16; Spermatogenesis-associated protein 16; spermatogenesis-related protein; SUPT16H; testicular tissue protein Li 185; Testis development protein NYD-SP12; testis-specific Golgi protein; unnamed protein product
基因别名: 4921511F01Rik; 4930503K02Rik; NYD-SP12; RGD1563726; SPATA16; SPGF6
UniProt ID: (Human) Q9BXB7, (Mouse) Q8C636
Entrez Gene ID: (Human) 83893, (Mouse) 70862, (Rat) 294932